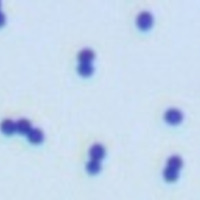

Neutrophil은 우리말로 호중구이고 가끔 중성구라고 부르기도 합니다.
Granulocyte (과립구)는 호중구가 대부분이고 호산구 (eosinophil)와 호염기구 (basophil)는 적은 비율을 차지합니다.
호중구 수 (neutrophil count)의 참고범위 (정상 수치)는 다음과 같습니다.
* 성인: 1.8~7.0 × 10^3/μL
* 소아: 1.0~8.5 × 10^3/μL (단, 소아는 연령대별로 더 세분화할 수 있습니다.)
호중구증가증 (neutrophilia, neutrophilic leukocytosis)
호중구증가증 (neutrophilia)은 참고범위 이상으로 절대호중구수 (absolute neutrophil count, ANC)가 증가한 것입니다.
절대호중구수 (ANC)는 총 백혈구 수에 호중구 감별계수를 곱하여 계산합니다.
호중구증가증의 원인은 급성 염증, 감염, 약물, 조직괴사, 종양 등이 있습니다.
위와 같은 경우는 원인 질환의 영향 중 하나로 호중구가 반응성으로 (reactive) 증가하는 것으로, 원인 질환이 치료되면 호중구 수치가 대개 정상화됩니다.
호중구가 비정상적으로 증식하는 혈액질환도 있습니다.
만성골수성백혈병 (chronic myelogenous leukemia, CML) 등의 골수증식질환, 만성 호중구성 백혈병 (chronic neutrophilic leukemia, CNL) 등이 이에 해당됩니다.
호중구증가증의 원인을 정리하면 다음과 같습니다.
- 급성 염증: 교원-혈관 질환, 혈관염
- 급성 감염: 세균성 감염, 일부 바이러스, 진균, 기생충 감염
- 약물, 독소, 대사이상: 스테로이드, 성장인자, 요독증, 케톤산증
- 조직괴사: 화상, 외상, 심근경색, 적혈구 용혈
- 생리적 이상: 스트레스, 운동, 흡연, 임신
- 종양: 암, 육종, 골수증식종양
호중구감소증 (neutropenia)
호중구감소증 (neutropenia)은 절대호중구수 (absolute neutrophil count, ANC)가 성인에서 1.5~2.0 × 10^3/μL 이하로 감소한 경우입니다. (보통 1.5 × 10^3/μL)
백혈구의 개수의 단위로 문헌에서는 ( ) × 10^9/L를 사용하기도 하지만 일상적으로는 ( ) × 10^3/μL을 더 많이 사용합니다.
(1L = 10^6 μL이므로 결국 똑같습니다.)
그래서 말로 소통할 때에는 앞의 수치 ( )에 10^3을 곱하여 ANC가 1500개 이하면 호중구감소증이라고 흔히 말합니다.
ANC 1000~1500개이면 경증, 500~1000개이면 중등도, 500개 미만이면 중증 (severe)입니다.
호중구 수치가 낮을수록 감염 위험이 높아집니다.
호중구 수치가 1500개 이하이더라도 1000개 이상이면 아직 감염 위험이 높아지지는 않습니다.
호중구 수가 1000개 미만이 되면 감염 위험이 높아지고, 호중구 수치가 500개 미만으로 매우 낮은 중증에서는 호중구 수가 너무 적어서 감염 증상은 오히려 모호하게 나타날 수 있습니다.
호중구 수가 500개 미만인 중증은 무과립구증 (agranulocytosis)이라고도 합니다.
호중구감소증의 발생 기전은 골수에서 생성부전, 제거율 증가, 순환과립구풀 (circulating granulocyte pool, CGP), 변연과립구풀 (marginal granulocyte pool, MGP) 분포 변화 등으로 설명합니다.
호중구감소증 (neutropenia)의 원인은 약물, 방사능, 독소, 내인성 결핍, 면역질환, 혈액학적 이상 등이 있는데, 정리하면 다음과 같습니다.
- 내인성 결핍: Fanconi anemia, Kostmann disease, cyclic neutropenia, Chediak-Higashi syndrome
- 면역질환: 교원-혈관 질환, 류마티스 관절염, 후천성면역결핍증 (AIDS, 에이즈)
- 혈액학적 이상: 거대적혈모구빈혈, 골수이형성증후군, 골수부전, 골수이식 전후
- 약물: 항암화학요법, 항생제 (chloramphenico 등), phenothiazine, benzodiazepine, 항갑상선제제, 항경련제, quinine, quinidine, indomethacin, procainamide, thiazide
- 심한 감염
- 방사능
- 독소 (알코올, benzene 화합물)
- 기아, 비장기능항진증
Reference
Laboratory medicine, 5th ed.
[관련 글]
2019/08/19 - [의학/진단검사의학] - 호염기구 (basophil), 비만세포 (mast cell) 기능, 역할, 모양, 차이점, 감별, 증가, 감소